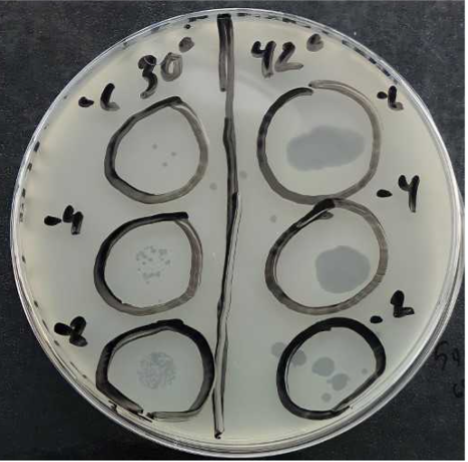
Solved A very amazing expert her on chegg helped me with a | Chegg.com

In addition to the information above, here is a curated collection of images related to Solved Of The Bacteria Used In This Experiment Chegg Com.
- | Chegg.Com
- Solved A Very Amazing Expert Her On Chegg Helped Me With A | Chegg.Com
- Solved Of The Bacteria Used In This Experiment, | Chegg.Com
- Solved 1. A Student In A Lab Identified An Unknown Bacteria | Chegg.Com
- Solved Bacteria | Chegg.Com
Find More About "Solved Of The Bacteria Used In This Experiment Chegg Com"
Explore exclusive offers, detailed information, and related services about solved of the bacteria used in this experiment chegg com from our trusted partners.
View Special Offers